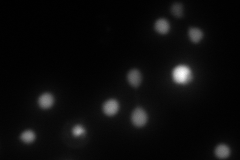
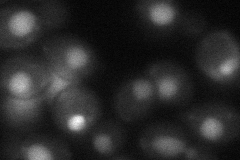

View description
Dihydrouridine synthase, member of a widespread family of conserved proteins including Smm1p, Dus3p, and Dus4p; modifies pre-tRNA(Phe) at U17
Localization:
Intensity:
Fold change:
Significance:
-
C’ GFP library in SD

nucleus27.29 -
N' NOP1pr-GFP in SD

nucleus113.186 -
N' TEF2pr-mCherry in SD
nucleus110.079 -
N' NATIVEpr-GFP in SD

nucleus39.1014 -
N' TEF2pr-VC and Cyto-VN in SD
nucleus46.6964 -
C’ GFP library in SD+DTT

nucleus22.80.83No -
C’ GFP library in SD+H2O2

nucleus25.960.95No -
C’ GFP library in Starvation Media

nucleus19.490.71Yes -
C’ GFP library on the background of Pup2-DaMP

nucleus -
C’ GFP library on the background of CCT mutant

nucleus31.02131.13662No
